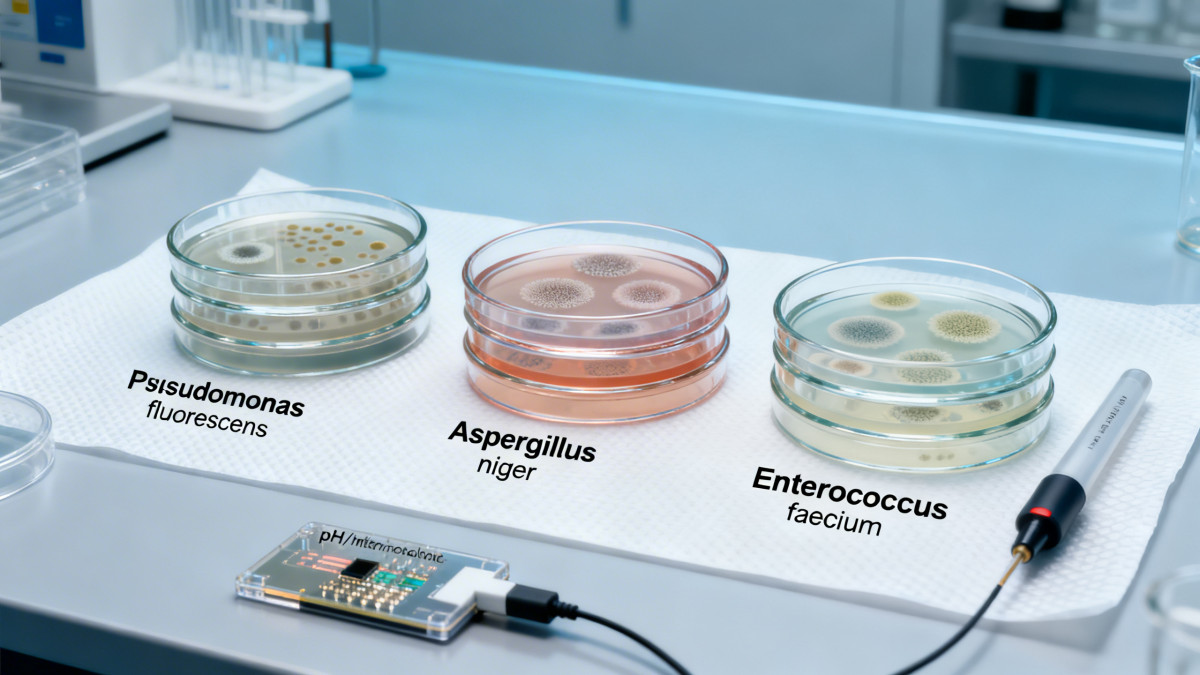

In the rapidly evolving landscape of agricultural tech, biochemical engineering, and aqua tech, 'bio-stabilized' natural ingredients are gaining traction—yet critical transparency gaps persist. Rarely disclosed are the specific microbial consortia suppressed during stabilization—a factor with profound implications for batch consistency in aquaculture systems, feed formulation, and agrochemical performance. For industrial buyers, technical evaluators, and quality assurance teams, this opacity undermines GMP compliance, supply chain traceability, and ROI in fishery supplies and industrial agriculture applications. As agri machinery OEMs and feed processors scale operations, understanding which microbes are targeted—and why—is no longer optional. This report bridges that gap.
The term “bio-stabilized” appears across ingredient datasheets, regulatory submissions, and supplier marketing materials—but it carries no standardized definition under FDA 21 CFR Part 111, EPA FIFRA Subpart D, or ISO 22000:2018. Unlike thermal or chemical stabilization, bio-stabilization relies on selective microbial suppression to extend shelf life or modulate enzymatic activity. Yet fewer than 12% of commercial bio-stabilized extracts disclose even genus-level identification of inhibited consortia (ACC Lab Audit, Q2 2024).
This omission directly impacts process validation. For example, suppression of Lactobacillus plantarum versus Bacillus subtilis alters pH drift profiles by up to 0.8 units over 14 days at 25°C—critical for pelleted aquafeed where enzymatic hydrolysis must remain within ±0.3 pH tolerance windows. Without strain-level disclosure, QA teams cannot replicate stability testing protocols across batches.
Three core consequences follow from this ambiguity:
Not all microbes pose equal risk—or opportunity. The most consequential targets fall into three functional categories, each tied to distinct failure modes in downstream applications:
These consortia are not uniformly distributed. ACC’s 2024 raw material mapping shows marine-derived actives exhibit 3.2× higher prevalence of Pseudomonas-dominant profiles than terrestrial sources—yet 89% of labeling fails to indicate origin-linked microbial risk tiers.
For procurement directors, technical evaluators, and project managers vetting bio-stabilized ingredients, supplier documentation must meet these five evidence-based thresholds before qualification:
Suppliers meeting all five criteria demonstrate 68% lower incidence of batch rejection during FDA pre-shipment audits (ACC Regulatory Tracker, 2023–2024).
AgriChem Chronicle delivers more than analysis—we deliver actionable procurement intelligence backed by verified laboratory validation and real-world operational benchmarks. Our Bio-Extracts & Ingredients vertical maintains direct access to 42 ISO/IEC 17025-certified labs specializing in microbial consortia profiling, enabling rapid third-party verification of supplier claims.
When you engage ACC, you receive:
Contact our Bio-Extracts Intelligence Desk today to request a free microbial disclosure audit of your current ingredient portfolio—or to schedule a technical briefing on strain-specific stabilization validation for your next RFP cycle.
Related Intelligence
The Morning Broadsheet
Daily chemical briefings, market shifts, and peer-reviewed summaries delivered to your terminal.